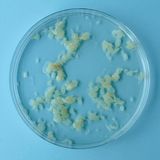
Gewebe, vierte Schwangerschaftswoche
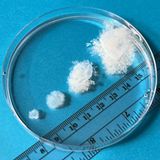
Entwicklungsstufen, Schwangerschaftswochen fünf bis acht

Schwangerschaft bedeutet, dass ein Mensch in einem anderen Menschen heranwächst. Bis man das, was da wächst, aber auch als Mensch erkennen kann, dauert es – und zwar länger, als die meisten wissen. In den Köpfen hat sich das romantische Bild des Miniatur-Babys festgesetzt und nicht das des unförmigen Zellklumpens, der erst nach vielen Wochen langsam Form annimmt. Wie weit die gängige Vorstellung vom Embryo im Bauch vor allem im Frühstadium von der Realität abweicht, zeigen Aufnahmen, die das us-amerikanische MYA Network nun geteilt hat. Das Netzwerk aus Ärzten, Aktivisten und Patienten setzt sich dafür ein, dass frühe Schwangerschaftsabbrüche in den USA in die reguläre Gesundheitsversorgung integriert werden.
Im Juni hat dort der US-Supreme Court das Recht darauf gekippt, eine Schwangerschaft beenden zu können. Bis dahin waren im ganzen Land Abtreibungen mindestens bis zur Lebensfähigkeit des Fötus erlaubt. Ganz anders jetzt. Schwangerschaftsabbrüche sind nun in 14 US-Bundesstaaten entweder untersagt oder nur stark eingeschränkt möglich, in 13 dieser Staaten ist eine Abtreibung selbst in den frühsten Schwangerschaftsstadien verboten.
Medizinerin Joan Fleischman, von MYA ist davon überzeugt, dass die Einstellungen bezüglich Schwangerschaftsabbrüchen beeinflusst von falschen Darstellungen sind. Bei ihrer Arbeit sei ihr klar geworden, "wie sehr Bilder im Internet und auf Plakaten – die menschenähnliche Eigenschaften in diesem frühen Entwicklungsstadium zeigen – die Kultur durchdrungen haben", sagte sie zu "The Guardian". Diese Bilder führten dazu, dass Patientinnen schon im Frühstadium ihrer Schwangerschaft, also bereits nach wenigen Wochen, erwarteten, "einen kleinen Fötus mit Händen zu sehen – ein entwickeltes Miniatur-Baby". Was sie stattdessen sehen: Zellgewebe.
Schwangerschaftsabbrüche weiter strafbar
Auch in Deutschland ist ein Schwangerschaftsabbruch laut Strafgesetzbuch weiterhin grundsätzlich strafbar. Obschon hierzulande Schwangere selbstbestimmter entscheiden können, ob sie das Kind bekommen möchten oder nicht. In der Regel ist ein Schwangerschaftsabbruch bis zur zwölften Woche nach der Empfängnis möglich. Liegt kein medizinischer oder kriminologischer Grund für die Abtreibung vor, muss die Schwangere sich gemäß der Beratungsregel in einem sogenannten Schwangerschaftskonfliktgespräch vorab beraten lassen.
Immerhin dürfen Ärzte in Deutschland jetzt auch öffentlich und ausführlich über Schwangerschaftsabbrüche informieren, nachdem der umstrittene Paragraf 219a Ende Juni vom Deutschen Bundestag ersatzlos aus dem Strafgesetzbuch gestrichen wurde. Zuvor hatten Ärzte mit Strafanzeigen und -verfolgung rechnen müssen. Alicia Baier von "Doctors for Choice Germany" nannte die Streichung im stern-Interview einen großen Erfolg. Sagte aber auch: "Der Schwangerschaftsabbruch wird weiter tabuisiert und stigmatisiert, daran wird auch die Streichung des Paragrafen 219a nichts ändern."
Quellen: MYA Network, The Guardian, Statistisches Bundesamt, Bundesministerium für Familie, Senioren, Frauen und Jugend